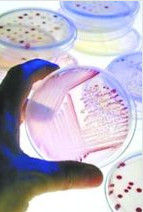
人造肉

簡介
人造肉是利用動物幹細胞製造。研究人員用糖、胺基酸、油脂、礦物質和多種營養物質“餵養”幹細胞,讓它不斷“長大”。
荷蘭馬斯特里赫特大學生物學教授馬克·波斯特說,全球第一個人造肉餅有望於明年8月或9月問世。研究人員說,人造肉有助人類在解決飢餓問題同時保護水源、土地和能源
發展過程
舊式人造肉
20世紀30年代後期,美國化學家波耶受汽車製造商福特雇用,研究汽車座墊套皮革的代用品。他在研究中發現,榨油和製造人造黃油後的大豆殘渣中,蛋白質含量豐富,並可纏繞成股。他從中受到啟發,想用這類物質製造清淡而又易消化的 “肉類”。但當時限於已擔負的科研任務,不能用更多的精力從事此研究,直到1953年,他才取得“人造肉”的發明專利。為製造“人造肉”,波耶把大豆殘渣製成細粉,與粘合液混合,直至混合物變成粘膠狀,然後象製造尼龍絲一樣用噴絲器噴出,經酸和鹽類淋洗,使絲凝固。再與調味劑混合,纏繞成股,可切片、切丁、絞碎。
人造肉
人造肉60年代,人造鹹豬肉開始在美國市場上銷售。由於肉類價格上漲和肉類中含有脂肪、膽固醇,很多人都認為組織化植物蛋白肉(TVP)銷售前景看好。
新式人造肉
這一種人造肉,是科學家利用幹細胞培育出“肉”。培養“人造肉”屬於醫學上的組織工程學的範疇,到目前為止,科學家們只能培育出指甲蓋大小的骨骼肌。對於人造肉,有人擔心在未來的某一天會在超市里吃到培養出的“人肉”。原料
生產“人造肉”,幹細胞無疑是最好的“原材料”。肌衛星細胞,又稱生肌幹細胞,因其負責肌肉的修復和再生,所以成為科學家們的首選。當然,也可以採用胚胎幹細胞,但這會引發一系列倫理問題:因為胚胎幹細胞具有全能性,也就是說它能分化出成體動物的所有組織和器官,除了肉之外,它們也有變成其他用途的可能。
製造方法
其一
美國馬里蘭大學的博士生賈森·馬西尼在《組織工程學》雜誌中撰文指出,他帶領的一個研究小組已經找到了在實驗室內製造“人造肉”的兩種方法。
一種方法是,他們首先從牛、豬、家禽或魚的肌肉組織中提取細胞,在一個薄膜上進行培育。他們發現,細胞會生長、擴張,然後從薄膜上脫落;等到脫落後的平面細胞群堆積到一定厚度時,就形成了肉;
馬西尼提供的另一種方法是在一種三維顆粒中培育肌肉細胞。這樣培育出的細胞組織可以用來製造肉製品,比如雞米花和碎牛肉。
其二
科學家班傑明表示:“我們找到一套方法,讓肉類在動物體外生長。”據悉,科學家們首先抽取出動物身上的“肌肉母細胞”,然後將其放在培養液中生長,接著倒入支架,放入生物反應器當中,藉此培育出動物肌肉纖維。這些人工培養出來的肌肉,最後將被用來製作肉類食品。
製作影響
細胞變異
美國與荷蘭的科學家正在研製利用動物的細胞組織,直接在實驗室當中培養出一種“人造肉”,完全擺脫了飼養和屠宰動物的傳統肉類生產方式。然而,這種“人造肉”的製造成本每公斤高達1萬美元。美國與荷蘭的科學家正研究以細胞培養的方式,製造出一種“人造肉”。科學家班傑明表示:“我們找到一套方法,讓肉類在動物體外生長。”據悉,科學家們首先抽取出動物身上的“肌肉母細胞”(myoblast),然後將其放在培養液中生長,接著倒入支架,放入生物反應器當中,藉此培育出動物肌肉纖維。這些人工培養出來的肌肉,最後將被用來製作肉類食品。
科學家表示這種用人工製造出來的“人造肉”可以保證絕對乾淨,從根本上杜絕瘋牛病以及口蹄疫等病毒感染,而且還可以加入有益人體健康的成分。不過這項研究仍還在實驗室階段,因為每公斤“人造肉”的生產成本約為1萬美元,相當於市面上普通肉類價格的1000倍以上。
國內知名專家、上海組織工程研究與開發中心的周廣東教授表示,大規模繁育人造肉的可能性很小,至少在目前來講,幾乎是難以做到的。
“所謂動物細胞與組織培養,是從動物體內取出細胞或者組織,模擬體內的生理環境,在無菌、適溫和豐富的營養條件下,使離體細胞或者組織生存、生長並維持結構和功能的一門技術。”周廣東教授表示,“但是想要大規模的繁育人造肉不太可能。”
周教授說,想要人工培育出的動物的肌肉,要把從動物身上切下的整塊肉分散成單個肌肉細胞再進行增值繁育。但是由於整塊組織中的肌肉細胞相對較少,因此取一斤肉只能獲得少部分的肌肉細胞。想利用這些肌肉細胞再培育出一斤肌肉,那么就需要這些肌肉細胞進行大量的增值。科研人員在實驗中發現,正常的細胞在體外培養超過15代以後,細胞發生變異轉化成腫瘤的可能性非常大,但肌肉細胞本身的增值能力有限,因此在培育的過程中就要用到晚期的細胞,而使用這種細胞只能產生兩種結果,一種就是已經老化的細胞死去,另一種能夠就是細胞發生癌變。
前景不樂觀
周廣東表示,細胞脫離體環境就處於非生理狀態,而非生理狀態下細胞的穩定性就較差。在體外培養細胞必須能夠維持和模擬細胞在體內生存的良好環境和物質代謝過程,為此必須提供必需的營養、適宜的PH、嚴格的無菌條件、滲透壓、培養器皿、溫度和二氧化碳等條件。即使是這樣的實驗環境也很難模擬出完整的人體環境,細胞的代謝、自我修復功能等等都會受到影響,因此所有的細胞在體外培養的過程中都會或多或少發生一些變化。例如,我們大腦中的一些細胞,如果在人體中也許一輩子都不會發生改變,但是在體外進行培養的過程中,幾年以後就會發生改變。“在實驗中培育肌肉組織,只是一種試驗,或者培育出人的肌肉組織臨床用於治療患者的功能性缺損,但是臨床治療對於培育條件的要求要比日常的實驗要求更高。”周廣東說。看來,想通過實驗室培養的方式“做”出人肉,實現起來還有許多問題要解決。
還有很多潛在的法律問題。比如在荷蘭,“人造肉”算不上食品,如果有人把“人造肉”賣給他人食用,會被罰款1000歐元。
製作意義
解決食品危機一些全球著名科學家2010年8月16日發布報告稱,全球總人口預計將在2050年達到90億,如果想在不破壞環境的情況下確保這些人獲得足夠的食物,可能需要推廣人造肉。
世界人口增長將引發食品危機
全球總人口將在本世紀中葉達到90億,需要大量的食品,或引發食品危機。一些研究結果表明,生產糧食的農戶將在2050年面臨一些環境限制,因為工業企業和消費者將會爭奪水資源。由美國科學家組成的一個團體稱,人口增加30億會導致水需求量增加一倍。美國科羅拉多大學教授KennethStrzepek表示,這意味著,2050年全球用於糧食灌溉的水量將減少18%。他說:“水需求量增長將給非洲北部、印度、中國和歐洲部分地區和美國西部造成嚴重的影響。”
傳統方法與新技術並重科學家提議人造肉
但來自全球許多國家不同專業的科學家通過英國皇家學院發表報告稱,雖然未來可供糧食生產的新耕地面積非常少,但將全球糧食供應量在未來40年內提高70%並不是一件無法完成的任務。
一些傳統的方法被認為是可以有效提高食品產量的方法,例如同時將富國和窮國的農作物用水量減少30-40%。如果開發中國家擁有更好的倉儲設施和超市,同時富國消費者只購買所需的食品,那么食品供應量將會顯著增加。
除了傳統方法,提高食品產量也需要使用新方法。亞洲和撒哈拉沙漠以南非洲地區的日常乳製品和肉製品需求量未來可能增長一倍,使用常規的家畜繁育方法應該可以滿足大部分需求,但不能全部滿足。國際家畜研究所科學家菲利普-桑頓博士稱,可以使用兩種方法增加全球奶製品和肉製品產量。他說:“一種是人造肉,一種是納米技術。”
新技術無法完全消除飢餓智慧財產權被壟斷阻礙新技術推廣
由英國政府首席科學家約翰-貝丁頓牽頭進行的一項針對未來全球食品供應的學術評估報告稱,即使採用基因改造和納米等新技術,仍然會有數億人因為氣候變化、水資源短缺和食品消費增長帶來的綜合作用而挨餓。
然而,一些研究報告稱,增加食品產量會碰到一些意想不到的障礙。來自英國和南非的經濟學家做出了最悲觀的預測,稱“為了創造新的綠色革命,人們必須在農業領域付出巨大的努力,但目前全球技術領域被掌握在七家國際公司手中。”倫敦國王大學詹妮弗-皮耶斯教授說:“這些企業擁有大量智慧財產權,使大眾和國際機構處於不利地位。這將對農業技術的全球推廣造成威脅。許多撒哈拉沙漠以南非洲地區國家可能無法生產足夠的食品滿足本國需求。已開發國家未來可以增加食品產量,但缺乏技術能力的國家將處於不利地位。”
外界反應
科學界對波斯特的做法仍有不少批評。原荷蘭研究項目的首席科學家,烏得勒支大學的亨克·哈格斯曼(HenkHaagsman)認為,如果波斯特想對實驗室人造肉進行市場化推廣的話,他必須回到培養胚胎幹細胞的路子上。使用成年動物的幹細胞造肉,只能得到單層的細胞組織;也許可以培養出有限的幾層,但是如果層數太多,細胞就無法呼吸,養分也無法達到組織中間,因此肉片肯定都很薄。 人造肉
人造肉澳大利亞莫納什大學的哲學家、倫理學家羅伯特·斯帕羅博士(Dr.Robert Sparrow)並不相信,人造肉會減少人們對肉的過度消費。他認為科學家耽於幻想,忽視了食品的社會和情感的意義,我們真正應當做的,是恢復當地食物生產的多樣性,並且採用更加生態友好的農業生產方式。
撇開環境和道德的問題不談,人造肉還有口感的問題。英國布里斯托大學的傑夫·伍德(Jeff Wood)說,口感是最難模仿的屬性,這與畜類的飲食習慣、年齡和烹飪方法都有關係。他認為,人造肉的口感可以用來做醬料較重的菜餚,如肉醬意粉中的碎牛肉,但實驗室里很難培養出羊排或沙朗牛排的替代品。有些人善於品嘗肉類味道的細微差別,就像葡萄酒的品酒師一樣。
波斯特也把口味的因素看得很重。考慮到脂肪可以改善肉的口感,使肉鮮嫩多汁,他的研究小組已經開始著手兩個新項目,一是培養脂肪組織,二是增加肉中的肌紅蛋白含量。肌紅蛋白是肌肉中最重要的鐵元素攜帶者,這正是味道的一個重要組成部分。研究人員先減少細胞的供氧量,之後細胞會產出過量的肌紅蛋白進行補償,他們還可以用咖啡因等其他刺激物培養細胞,或者讓肌肉組織更頻繁地進行鍛鍊。
如何烹飪人造肉是另一個問題。波斯特已聘請了食品技師,以研究人造肉在加熱過程中會出什麼狀況。
“我們想知道它們是會凝結成肉餅還是會散架,我們是否需要設法把它們粘合在一起……”
即便他烹調成功,仍有很多潛在的法律問題,例如,人造肉算不上食品,在荷蘭如果把人造肉賣給他人食用,會被罰款1000 歐元。對此,波斯特回答:“誰又會在乎呢?”
科學界對“人造肉”仍有不少批評。其中之一,是從道德方面出發,澳大利亞莫納什大學的哲學家、倫理學家羅伯特・斯帕羅博士認為,“人造肉”並不會減少人們對肉的過度消費。他認為科學家耽於幻想,忽視了食品的社會和情感的意義。
另一種主要聲音則源自“人造肉”的口感問題。英國布里斯托大學的傑夫・伍德說,口感是最難模仿的屬性,有些人善於品嘗肉類味道的細微差別,就像葡萄酒的品酒師一樣。如何烹飪也是一個問題,比如它們在烹飪過程中是否會出現凝結或者散架的問題?
當然,對於“人造肉”的製作材料,大多數普通人有更直接的想法――有人說:“是不是從自己身上抽取少少肌肉纖維,就能自給自足?科幻小說里出現的循環食物也不再是夢了。”尤其對日本人研究出的“便便肉”,有不少人表示無法接受,“那些地下加工窩點應該最有興趣,因為他們有希望進一步和公廁集團總公司合作,開發出相應的唐僧肉、地攤牛排等產品吧?”有人說:“雖然平時吃的米飯也是屎尿澆灌長大的,但那和直接攝取還是不同的。”也有人說:“人類遲早得這么吃么?當死亡滅絕和重口味相比,你會怎么選擇呢?”
現狀
有專家指出,動物細胞與組織培養,是從動物體內取出細胞或者組織,模擬體內的生理環境,在無菌、適溫和豐富的營養條件下,使離體細胞或者組織生存、生長並維持結構和功能的一門技術。但是想要大規模的繁育人造肉不太可能。
想要人工培育出的動物的肌肉,要把從動物身上切下的整塊肉分散成單個肌肉細胞再進行增殖繁育。但是由於整塊組織中的肌肉細胞相對較少,因此取一斤肉只能獲得少部分的肌肉細胞。想利用這些肌肉細胞再培育出一斤肌肉,那么就需要這些肌肉細胞進行大量的增殖。科研人員發現,正常的細胞在體外培養超過15代以後,細胞發生變異轉化成腫瘤的可能性非常大,但肌肉細胞本身的增殖能力有限,因此在培育的過程中就要用到晚期的細胞,而使用這種細胞只能產生兩種結果,一種就是已經老化的細胞死去,另一種可能就是細胞發生癌變。
目前NASA已經用魚肉組織試驗製造出少量魚肉。
截至2009年的11月為止,科學家們只能培育出小塊的骨骼肌,只有指甲蓋那么大。
生產成本
每公斤“人造肉”的生產成本約為1萬美元,相當於市面上普通肉類價格的1000倍以上。
優點
1、動物可以免受被宰殺的痛苦。
2、由於人們不再飼養牲畜和家禽,也就不用再擔心瘋牛病、豬流感、禽流感這些疾病了。
3、據聯合國糧農組織統計,畜牧業占了世界耕地面積的70%,相對於飼養,人工培育肉製品所占得地方肯定小得多。
4、根據聯合國糧農組織的數據,牲畜、禽類排出的溫室氣體占全世界總量的18%,超過全球汽車排出的溫室氣體總和。如果人類不再飼養牲畜和禽類,全球變暖問題將得到緩解。
5、從根本上杜絕瘋牛病以及口蹄疫等病毒感染,而且還可以加入有益人體健康的成分。
6、從根本上解決人類的飢餓問題。
7、可以為遠征月球和火星的夢想提供重要的生存手段,這比攜帶大量脫水耐儲食品和在太空種植農作物都要方便得多。
擔憂
人類一旦能夠成功地生產出“人造肉”,那么就可以在超市里買到人造的牛肉、魚肉、雞肉、豬肉,甚至可以買到鯨魚、海牛、海豚的肉,但最可怕的是,“克隆人肉”也可能會出現在超市的貨架上!那吃人肉就會真正的走入平常百姓家。
現在看來,即使“人造肉”能夠成功地生產出來,它要走上市場,估計還會遇到重重障礙,但在市場經濟中,市場完全可以衝破一切障礙。
口感
一位俄羅斯電視台記者親口嘗了一條人造肉。這名記者坦言,肉條沒有給自己留下什麼印象。人造肉沒有血管,看起來不像真肉,更像扇貝。波斯特說,他會給人造肉加上適量脂肪以及人造血管,讓它變得顏色更鮮艷,無論從外形還是口感上都與真肉更接近。
波斯特希望有一天,研究人員能讓人造肉變得更健康,比如添加更多不飽和脂肪以及各種營養素。“我的想法是,既然我們能在實驗室中製造出肉,就能讓它有多種變化,最終變成更健康的肉,”他說。
最新動態
人造肉首次培育成功 可減少溫室氣體
2009年12月2日,英國《每日電訊報》報導,荷蘭研究人員首次在實驗室中培育出了類似濕豬肉的物質。研究人員正在想方設法改善這種物質的肌肉組織,希望某一天人們會食用並且喜歡這種肉類。
荷蘭愛因霍芬科技大學的研究人員從一隻活豬的肌肉上提取出了一些細胞,然後把它們放進其它動物肉製做的肉湯中。接著,這些細胞開始成倍增長,並且產生出肌肉組織。該大學生理學教授馬克·珀斯特稱,如果他們能夠找到一種人工“訓練”肌肉的方法,改善肌肉的結構和質量,肌肉組織就能變成牛肉一類的物質。珀斯特表示,今後或許可從一頭動物身上提取一塊肉,製造出以前需要100萬頭動物才能提供的肉量。根據預測,到2050年,肉類和乳製品的消費將翻一番。
科學家認為,這種實驗室生產出來的肉類能減少與真正的動物相關的溫室氣體排放。目前家畜產生的甲烷排放約占全球溫室氣體的18%。
該項目獲得了荷蘭政府和一家香腸製造商的支持,接下來,研究人員還會使用鮪魚的肌肉細胞來製造人造魚片。雖然迄今為止還未曾有人食用過他們的產品,但研究人員相信,這種人造肉可能於5年之內出現在超市的貨架上。
一些素食組織和動物權益組織“善待動物組織(Peta)”均認為,如果肉類不是來自於死去的動物,就沒有倫理異議。而素食協會則表示,最大的問題是人們怎么能保證吃的是人造肉而不是被屠宰的動物肉。從人們的信任程度來講,很難進行分類和識別。
問世時間
2011年11月,荷蘭馬斯特里赫特大學生物學教授馬克·波斯特說人造肉樣本,全球第一個人造肉餅有望於2012年8月或9月問世。研究人員說,人造肉有助人類在解決飢餓問題同時保護水源、土地和能源。波斯特表示,這個肉餅只為證明“人造肉”這一概念,不意味著大規模生產人造肉條件成熟,因為首個人造肉餅的造價高達25萬歐元(約合34.5萬美元)。
當前,波斯特已經造出多條“肉條”,每條長約2.5厘米,寬不到1厘米,薄得近乎透明。他說,把大約3000條這樣的肉條堆在一起,就可以製作全球第一個人造肉餅。
波斯特希望有一天,研究人員能讓人造肉變得更健康,比如添加更多不飽和脂肪以及各種營養素。“我的想法是,既然我們能在實驗室中製造出肉,就能讓它有多種變化,最終變成更健康的肉,”他說。

